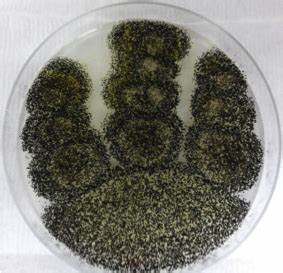

Fungi
Health
Science
Food
Disease
Medical Information
Food Safety
Disease Awareness
Aspergillosis
Otomycosis
Studies have also shown that some Species of Aspergillus Niger produce a dangerous Toxin called OCHRATOXIN which can cause Damage of the Kidneys
More studies are still trying to link it with its role in Cancer
Here is a link
pubmed.ncbi.nlm.nih.gov
More studies are still trying to link it with its role in Cancer
Here is a link
pubmed.ncbi.nlm.nih.gov
Aspergillus Flavus produces a toxin called Aflatoxin.
These chemicals are difficult to destroy even with Heat or cooking
Aflatoxins are known to cause Cancer of the Liver, Acute Hepatitis, Reduce the Immunity
A reason not to buy Cheap spoilt tomatoes in the Market.
So unhealthy
These chemicals are difficult to destroy even with Heat or cooking
Aflatoxins are known to cause Cancer of the Liver, Acute Hepatitis, Reduce the Immunity
A reason not to buy Cheap spoilt tomatoes in the Market.
So unhealthy
Don't forget to share and follow me for more Health tweets, Health sessions, health tips, space and conversations
@the_beardedsina
@the_beardedsina
Loading suggestions...